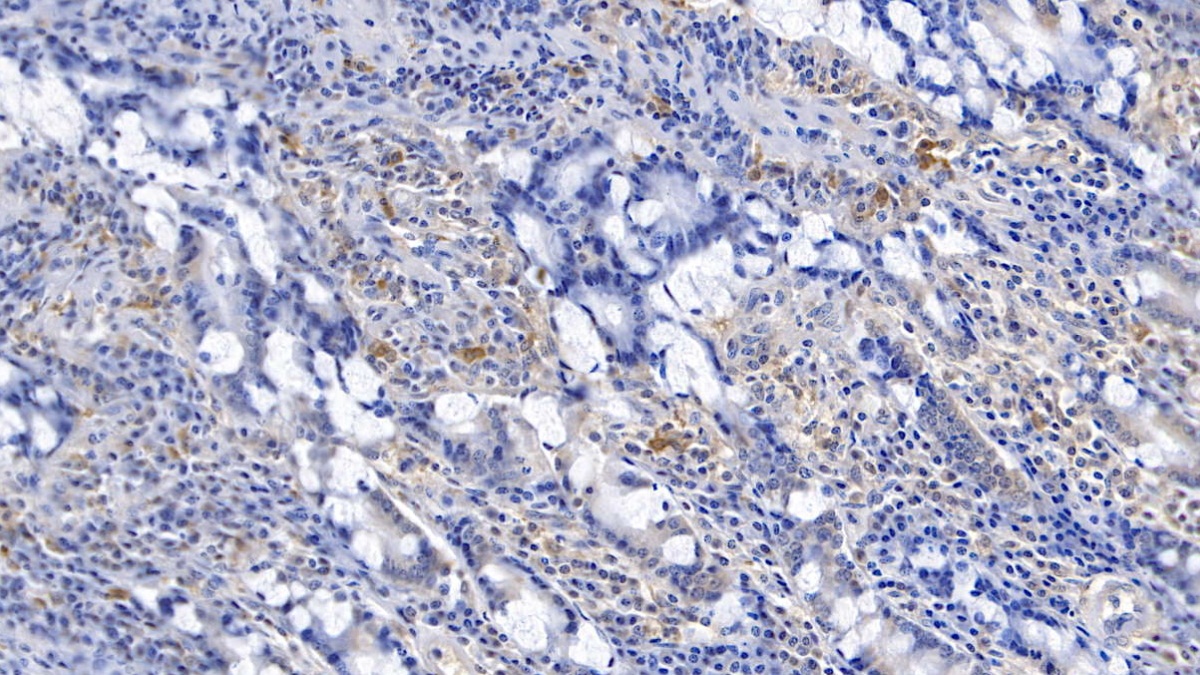

Polyclonal Antibody to Gelsolin (GSN) 

GS; AGEL; ADF; Brevin; Gelsolin Amyloidosis,Finnish Type; Actin-depolymerizing factor
Overview
Properties
- Product No.PAA372Hu05
- Organism SpeciesHomo sapiens (Human) Same name, Different species.
- ApplicationsWB; IHC
If the antibody is used in flow cytometry, please check FCM antibodies.
Research use only - DownloadInstruction Manual
- CategoryTumor immunityInfection immunity
- SourcePolyclonal antibody preparation, Host Rabbit
- Ig Type IgG, Potency n/a
- PurificationAntigen-specific affinity chromatography followed by Protein A affinity chromatography
- LabelNone
- Immunogen RPA372Hu05-Recombinant Gelsolin (GSN)
- Buffer Formulation0.01M PBS, pH7.4, containing 0.05% Proclin-300, 50% glycerol.
- TraitsLiquid, Concentration 0.5mg/ml
Sign into your account
Share a new citation as an author
Upload your experimental result
Review

Contact us
Please fill in the blank.
Specifity
The antibody is a rabbit polyclonal antibody raised against GSN. It has been selected for its ability to recognize GSN in immunohistochemical staining and western blotting.
Usage
Western blotting: 0.5-2µg/mL
Immunohistochemistry: 5-20µg/mL
Immunocytochemistry: 5-20µg/mL
Optimal working dilutions must be determined by end user.
Storage
Store at 4°C for frequent use. Stored at -20°C in a manual defrost freezer for two year without detectable loss of activity. Avoid repeated freeze-thaw cycles.
Stability
The thermal stability is described by the loss rate. The loss rate was determined by accelerated thermal degradation test, that is, incubate the protein at 37°C for 48h, and no obvious degradation and precipitation were observed. The loss rate is less than 5% within the expiration date under appropriate storage condition.
Organism Species More: Sus scrofa; Porcine (Pig)Giveaways
Increment services
-
 Antibody Labeling Customized Service
Antibody Labeling Customized Service
-
 Protein A/G Purification Column
Protein A/G Purification Column
-
 Staining Solution for Cells and Tissue
Staining Solution for Cells and Tissue
-
 Positive Control for Antibody
Positive Control for Antibody
-
 Tissue/Sections Customized Service
Tissue/Sections Customized Service
-
 Phosphorylated Antibody Customized Service
Phosphorylated Antibody Customized Service
-
 Western Blot (WB) Experiment Service
Western Blot (WB) Experiment Service
-
 Immunohistochemistry (IHC) Experiment Service
Immunohistochemistry (IHC) Experiment Service
-
 Immunocytochemistry (ICC) Experiment Service
Immunocytochemistry (ICC) Experiment Service
-
 Flow Cytometry (FCM) Experiment Service
Flow Cytometry (FCM) Experiment Service
-
 Immunoprecipitation (IP) Experiment Service
Immunoprecipitation (IP) Experiment Service
-
 Immunofluorescence (IF) Experiment Service
Immunofluorescence (IF) Experiment Service
-
 Buffer
Buffer
-
 DAB Chromogen Kit
DAB Chromogen Kit
-
 SABC Kit
SABC Kit
-
 Long-arm Biotin Labeling Kit
Long-arm Biotin Labeling Kit
-
 Real Time PCR Experimental Service
Real Time PCR Experimental Service
Citations
- Gelsolin in Cerebrospinal Fluid as a Potential Biomarker of EpilepsySpringerLink: 3585r8h46q7r0171
- Treatment with gelsolin reduces brain inflammation and apoptotic signaling in mice following thermal injuryBioMed: 17422094
- Application of iTRAQ quantitative proteomics in identification of serum biomarkers in breast cancerIEEE: 6098563
- Investigation of the actin scavenging system in pre-eclampsiaPubmed: 24239294
- Proteomic Study Reveals Plasma Protein Changes in Congenital Heart DiseasesPubmed: 24565402
- The role of plasma gelsolin in cardiopulmonary bypass induced acute lung injury in infants and young children: a pilot studyPubmed:Pmc4132929
- Gelsolin: Role of a Functional Protein in Mitigating Radiation InjuryPubmed:25164111
- Plasma gelsolin and matrix metalloproteinase 3 as potential biomarkers for Alzheimer diseasePubMed: 25864780
- Comparative mass spectrometric and immunoassay‐based proteome analysis in serum of Duchenne muscular dystrophy patientsPubmed:26680509
- Comparative mass spectrometric and immunoassay-based proteome analysis in serum ofDuchenne muscular dystrophy patients.pubmed:26680509
- Serum gelsolin levels in aneurismal subarachnoid hemorrhage: Preliminary results.pubmed:28365030
- Urine-Based Biomarkers for Alzheimer's Disease Identified Through Coupling Computational and Experimental MethodsPubmed:30040720
- Plasma gelsolin level predicts acute kidney injury after cardiopulmonary bypass in infants and young childrenPubmed:29427164
- Production and Secretion of Gelsolin by Both Human Macrophage-and Fibroblast-like Synoviocytes and GSN Modulation in the Synovial Fluid of Patients with Various …Pubmed:35327525